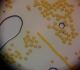

|
Last upload 2026-04-03 09:11:41
All photos copyrights reserved
Recent reports
Common Snipe
Gallinago gallinago - 2026-04-03 Rallus
Pūce (nenoteikta)
Strigidae sp. - 2026-04-03 Kurmata
Woodlark
Lullula arborea - 2026-04-03 Gaidis Grandāns
Common Snipe
Gallinago gallinago - 2026-04-03 dagnis
Northern Lapwing
Vanellus vanellus - 2026-04-03 dagnis
European Robin
Erithacus rubecula - 2026-04-03 Erebila
Common Crane
Grus grus - 2026-04-03 Gaidis Grandāns
|
Recent comments on observations
Uz kā auga? Uz kritalas? Ja to, protams, var atcerēties :)) Ziemelmeita Paldies,Julita,par labojumiem un precizējumiem! mufunja Varbūt Ph.album, bet dikti skaists paraugs, pārbaudīšu Kiwi Paldies, Uģi, par sugas noteikšanu! Mari Mari Tās kārtīgās armijas rindās un blīvās čupiņas auga vienā vietā? Un, jā, visi varētu būt viena suga. Paldies, interesanti! Pats mežs - vecs? Jo līdz šim šī suga atrasta tikai izcilos, vecos mežos. finesse Mari Ja būs paraugs, tad pārbaudīšu, vai nav Ph.leucopus Par melno nav pārliecības, vai tā nav cieta sēne, bet tām rozā vajadzētu būt aveņgļotsēnēm Mežirbe777 Vienā bildē varbūt baltu dibenu redz... Tad mainām sugu uz S. difformis? zemesbite Protams, mikroskopiski derētu pārbaudīt Ņemot vērā, ka purvā, tai vajadzētu būt potenciāli aizsargājamajai sugai Tur varētu būt pat vairākas sugas vigulis Šai sugai prasās foto vai noteikšanas pazīmju aprakstu. Vai tomēr nebūs lielais ķīris? vigulis Šai sugai prasās foto vai noteikšanas pazīmju aprakstu. Vai tomēr nebūs lielais ķīris? zemesbite Siona a.b Varbūt arī tā. Ierakstīt nepaguvu.. forelljjanka Mazais dzenis.Agrākajam novērojumam Latvijā nepietiks.;) Mežirbe777 adata ekologs Manuprāt, koku kamene (Bombus hypnorum). adata Mežirbe777 Mežirbe777 adata Tik skaisti izkritusi no kausiņiem! megemege adata Pēc staipīgajiem kapilīcija pavedieniem un dzeltenās krāsas teiktu, ka režģa gļotsēne. Vai aplikācija ir atjaunināta? spiigana mufunja Mežirbe777 Mežirbe777 zane_ernstreite Varētu būt Reticularia lycoperdon zemesbite Vai dieniņ, kā tādu kunkulīti var ieraudzīt! Lieliski! :) zemesbite Pēdējā foto zobiņi labi redzami. ekologs Koksngrauzis (Obrium cantharinum). Lietuviete Liels paldies, Edgar, par sugas noteikšanu! guta7 Paldies par skaidrojumu. Ilgi cīnījos, lai tiktu skaidrībā. ekologs adata Ziemelmeita Paldies, kāpurs nokrita, vēl bildes dabūt nesanaca. Jā, grūti saprast, bet vismaz R.inqisitor tas nav. Ziemelmeita Vienīga bilde. Pietuvināju šo pašu, bet nekas īpaši labāks nav. Šis neizskatās pēc R.inqisitor kāpura. Varbūt kāda tuvāka bilde? Ziemelmeita adata Vai tik nebūs medainā bumbulīte? Augļķermeņi vertikāli izstiepti, sporu mākonis ciešā klājienā. Siona ekologs zemesbite pustumsa Iespējams peļu klijāna ligzda, kurš tur blakus cīnījās ar vārnām pustumsa Šķiet plucināja vistu no blakus esošās mājas pagalma Lielais meža raibenis sāk lidot ap jāņiem :) ekologs Gredzens HA39.922. Aizsūtīšu kolēģiem. adata ekologs Zeltmalu airvabole (Dytiscus marginalis). megemege Amanda S.gracilis/hyperopta, būtu skaidrāk jāredz sīkās sporas adata Piekrītu Julitai, gļotsēni neatgādina. Vairāk tā kā pēc sēnes - fleogenas izskatās.. Ziemelmeita Ivars Leimanis Ticamāk kalnu divzobe Orthodicranum montanum. Dubults Mani vienmēr samulsina šis tik pazīstamais saīsinājums - C. nigra - attiecībā uz gļotsēnēm :) Vīksna Vai tiešām pelēkais tāds koks un tik agri zied ? C.nigra tā izjukt kā alta nemaz nespēj. Kaut ko te jāizvēlas, izvēlos retāko. Amanda marsancija LMM 25.marts, 19:49 Macrogastra borealis (latesriata) LMM 25.marts, 19:47 Mežirbe777 Chaenotheca furfuracea (L.) Tibell Mežirbe777 Un, jā, F.intermedia plazmodijs ir krēmkrāsas, un tāds te arī ir. Mežirbe777 ekologs Šī būs no Entomobryomorpha kārtas. Izskatās, atradne atzīmēta neprecīzi - priežu mežā, kas neatbilst foto redzamajai vietai - pļavā. Puķu Ilze Puķu Ilze Laimeslācis Laimeslācis Paldies, Julita, par labojumiem un komentāriem! VijaS Tur pa apkārtni bija desmitiem paciņu visās iespējamās stadijās. Plantācijas :) Ziemelmeita Neatradu, iespējams nav nobriedis un aizvests atpakaļ uz mežu, neatceros. Siona Ir uz egles, jā! Man arī tā likās, dzīvē skatoties uz tām piepēm.. erts erts Ziemelmeita Vīksna Ja tas ir uz egles, varētu būt egļu cietpiepe Zemesriekstu / konglomerāta pumpurīte. Tās arī nobriedušas "uz aci" grūti atšķirt. Siona Varētu būt sēņmuša Agathomyia wankowiczii.., bet es nezinu, vai kāds cits neveido kaut ko līdzīgu.. zemesbite Ziemelmeita ekologs Skrejvabole (Badister bullatus). Reticularia lobata? Šim jau gan sporas vajadzētu paskatīt.. Man šķiet, ka paresninājums tomēr ir. Un jaunas tā izskatās, ir redzētas. Jā, Ilze, nu jau es ne tikai domāju, bet daru! :D. Nieka 6+ gadi pagājuši. Ir kas līdzīgs redzēts, kas nebija gļotsēne, bet saprast, kas tas ir, nevarēja Uzticīgs draugs. Mēģināšu dabūt gredzenošanu un ziemošans vietu. Ziemelmeita Paldies,Julita! Paraugu paņēmu, brīvākā brīdī paskatīšos mikroskopā. Varbūt ir, bet es laikam mikroskopētu drošai noteikšanai :) erts AE 77 Daugavpilī novērots 12.gadu pēc kārtas. Vīksna fufuks Mazulis no Kaņiera, 11.06.2024 dabūja pasi 2024. gada oktobrī Lietuvā netālu no Rusne ekologs ekologs ekologs ekologs Entomobryomorpha kārta. Iespējams, Entomobrya corticalis. ekologs Šī izskatās no Poduromorpha kārtas. ekologs Entomobryomorpha kārta, Orchesella sp. Iespējams Orchesella cincta. ekologs ekologs Jā, piekrītu. Pievienoju. Tagad tik būtu jāizskata iepriekšējie novērojumi un jānomaina nosaukumi. ekologs ekologs ekologs artis113 Nē, diemžēl vairāk foto un paraugu nav. Arī pārāk tāla lokācija, lai apsekotu un ievāktu paraugu. Šis būtu agrākais zināmais novērojums pavasarī. Bez pierādījumiem nevar uzskatīt par ticamu. SashaO 20.marts, 10:21 https://youtu.be/SLVpBS__0fI?is=MphbUujvrJH2G3h1 Ivars Leimanis ivars Tās ir izžuvušas/sakaltušas sēnes Mežirbe777 |